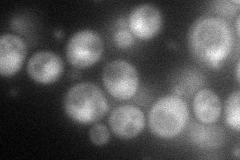
YMR182C
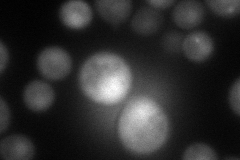
YMR182C
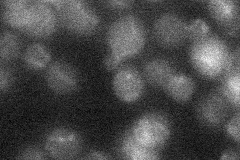
YMR182C
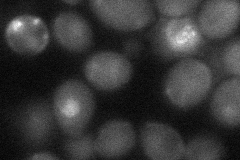
YMR182C

View description
Putative transcriptional repressor with proline-rich zinc fingers; overproduction impairs cell growth
Localization:
Intensity:
Fold change:
Significance:
-
C’ GFP library in SD

nucleus23.29 -
N' NOP1pr-GFP in SD
cytosol,nucleus65.8925 -
N' TEF2pr-mCherry in SD
punctate,nucleus75.2091 -
N' NATIVEpr-GFP in SD
below threshold16.314 -
N' TEF2pr-VC and Cyto-VN in SD
cytosol36.3722 -
C’ GFP library in SD+DTT

nucleus22.280.95No -
C’ GFP library in SD+H2O2

nucleus17.790.76Yes -
C’ GFP library in Starvation Media

nucleus18.510.79Yes -
C’ GFP library on the background of Pup2-DaMP

nucleus -
C’ GFP library on the background of CCT mutant

nucleus28.29021.21414No
